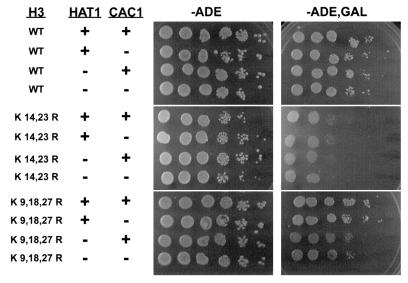
FIG. 7.

Abstract
The modification of newly synthesized histones H3 and H4 by type B histone acetyltransferases has been proposed to play a role in the process of chromatin assembly. The type B histone acetyltransferase Hat1p and specific lysine residues in the histone H3 NH2-terminal tail (primarily lysine 14) are redundantly required for telomeric silencing. As many gene products, including other factors involved in chromatin assembly, have been found to participate in both telomeric silencing and DNA damage repair, we tested whether mutations in HAT1 and the histone H3 tail were also sensitive to DNA-damaging agents. Indeed, mutations both in specific lysine residues in the histone H3 tail and in HAT1 resulted in sensitivity to methyl methanesulfonate. The DNA damage sensitivity of the histone H3 and HAT1 mutants was specific for DNA double-strand breaks, as these mutants were sensitive to the induction of an exogenous restriction endonuclease, EcoRI, but not to UV irradiation. While histone H3 mutations had minor effects on nonhomologous end joining, the primary defect in the histone H3 and HAT1 mutants was in the recombinational repair of DNA double-strand breaks. Epistasis analysis indicates that the histone H3 and HAT1 mutants may influence DNA double-strand break repair through Asf1p-dependent chromatin assembly.
The packaging of eukaryotic genomes into chromatin imposes constraints on the many cellular processes that require access to chromosomal DNA. The posttranslational acetylation of the core histones has emerged as one important mechanism by which cells regulate the structure and accessibility of chromatin. Histone acetylation is a reversible modification that occurs on lysine residues located in the NH2-terminal tail domains of each core histone. Acetylation alters both the charge and structure of the lysine residues. Therefore, histone acetylation is likely to influence chromatin structure through its impact on both histone-DNA and histone-protein interactions.
The acetylation of the core histone NH2-terminal tails is catalyzed by histone acetyltransferases. Histone acetyltransferases can be classified into two distinct groups (type A and type B) on the basis of cellular localization and substrate specificity. Type A histone acetyltransferases are nuclear enzymes capable of acetylating histones that are packaged into chromatin. In recent years, numerous type A histone acetyltransferases have invariably been demonstrated to be transcriptional activators, clearly establishing their central role in the positive regulation of gene expression (reviewed in references 8, 15, and 37).
Type B histone acetyltransferases were originally defined as cytoplasmic enzymes that acetylate free but not chromatin-associated histones (3). The first type B histone acetyltransferase was isolated from Saccharomyces cerevisiae and is composed of two subunits, Hat1p and Hat2p (29, 41). Hat1p, the catalytic subunit of the enzyme, specifically acetylates lysine residues at positions 5 and 12 of free histone H4 (29, 41). Hat2p, a yeast homolog of the mammalian Rbap46 and Rbap48 proteins, is a regulatory subunit that increases the activity of Hat1p by promoting the interaction of Hat1p with the histone H4 NH2-terminal tail (41, 44, 45). The Hat1p-Hat2p complex appears to be evolutionarily conserved, as type B histone acetyltransferases isolated from a number of widely divergent organisms have identical subunit compositions (13, 24, 35, 58).
Type B histone acetyltransferases are thought to be involved in the acetylation of newly synthesized histones. Soon after its synthesis, histone H4 is acetylated on lysines 5 and 12, a pattern that is highly conserved throughout eukaryotic evolution (10, 48, 54). Newly synthesized histone H3 is also acetylated in many organisms but not in a strict pattern (3, 30, 54). Following their assembly into chromatin, the newly synthesized histones are deacetylated during chromatin maturation (4, 25). The temporal correlation of this acetylation-deacetylation cycle with the process of de novo chromatin assembly suggests that this transient acetylation plays a role in histone deposition.
Despite its evolutionary conservation, in vivo evidence of a role in the chromatin assembly pathway for the acetylation of newly synthesized histones by type B histone acetyltransferases has proven elusive (2, 39, 57). In S. cerevisiae, neither deleting the HAT1 gene nor mutating histone H4 lysine residues 5 and 12 causes a decrease in cell viability (29, 36, 41, 59, 64). The lack of a significant growth defect associated with these mutations may be explained by apparent redundancies in the process of chromatin assembly. For example, there are at least two histone chaperones, CAF-1 (Cac1p, Cac2p, and Msi1p in S. cerevisiae) and RCAF (Asf1p in S. cerevisiae), that can target the assembly of histone H3/H4 tetramers onto newly replicated DNA (26, 27, 53, 56, 59). Either of these chaperones can be deleted from S. cerevisiae without the loss of cell viability, which suggests that there are multiple pathways of chromatin formation. In addition, functional redundancy may exist between the acetylation of newly synthesized histone H3 and newly synthesized histone H4. Mutating lysine residues 5, 8, and 12 of histone H4 in the absence of the histone H3 NH2-terminal tail causes a significant defect in chromatin assembly and cell death (36). In addition, we have recently demonstrated that specific lysine residues in the histone H3 NH2-terminal tail (primarily lysine 14) and the Hat1p-dependent acetylation of histone H4 are redundantly required for telomeric silencing (28).
To better understand the in vivo role of type B histone acetyltransferases, we have sought to identify additional cellular processes that are influenced by the activity of Hat1p. An examination of a potential role for Hat1p in DNA repair was undertaken based on two factors. First, several DNA repair pathways require the synthesis of new DNA, which must then be reassembled into chromatin. Hence, the stable repair of damaged DNA might be sensitive to defects in chromatin assembly. Second, an intriguing link between telomeric chromatin structure and DNA damage repair has recently come to light. A number of factors, such as the yeast Ku protein homologs Yku70p and Yku80p, the silent chromatin proteins Sir2p, Sir3p, and Sir4p, the DNA damage checkpoint proteins Mec1p, Mec3p, and Rad53p, and the histone chaperones Cac1p and Asf1p, have all been shown to affect both telomeric silencing and DNA damage repair (reviewed in references 6, 34, and 51).
We have now determined that both Hat1p and specific lysine residues in the histone H3 NH2-terminal tail play a role in DNA damage repair. Specifically, the data presented here demonstrate that histone H3 and Hat1p contribute to the recombinational repair of DNA double-strand breaks.
MATERIALS AND METHODS
Plasmids.
Plasmids used to introduce alleles encoding histone H3 with lysine-to-arginine mutations have been described previously (28). Lysine-to-glutamine mutations at positions 14 and 23 of histone H3 (K14,23Q) were generated by site-directed mutagenesis of pMP3 (Quik-Change site-directed mutagenesis kit; Stratagene). Mutant alleles were confirmed by DNA sequencing. Plasmid pGALHO-pRS412 (a generous gift from M. DuBois) was constructed by inserting a SalI-EcoRI fragment containing the GAL-HO construct (a galactose-inducible promoter fused to the HO gene) from pGAL-HO into SalI- and EcoRI-digested pRS412 (20).
Yeast strain construction.
Yeast culture and genetic manipulation were done by standard methods (1, 17). The genotypes of all strains used in this study are given in Table 1. MPY201 was constructed as follows. UCC1203-7a, a segregant isolated from a cross between BY4704 (7) and UCC1110 (which is genetically identical to UCC1111 [28]), was transformed with pRM200U [(URA3 CEN ARS)-HHF2-HHT2] (a generous gift from R. Mann and M. Grunstein [60]). Cells that had lost pRS412 [(ADE2 CEN ARS)-HHF2-HHT2] were isolated as red, Ade− colonies (UCC1118). The ADE2 gene was then placed on the right arm of chromosome V of UCC1118 by transformation with EcoRI-digested pHR10-6 to generate UCC6584 (52). MPY201 was then made by PCR-mediated gene disruption of LEU2 with HIS3. MPY202 was generated from MYP201 by deletion of the HAT1 gene by transformation with EcoRI- and HaeII-digested pHAT1::LYS2 (41).
TABLE 1.
S. cerevisiae strains used in this study
| Straina | Genotype | Reference or source |
|---|---|---|
| BY4704 | MATa | 7 |
| UCC1110 | MATα adh4::URA3-TEL (VII-L) hhf1-hht1::LEU2 hhf2-hht2::MET15/pRS412 (ADE2 CEN ARS)-HHF2-HHT2 | 28 |
| UCC1203-7a | MATα hhf1-hht1::LEU2 hhf2-hht2::MET15/pRS412 (ADE2 CEN ARS)-HHF2-HHT2 | D. Gottschling |
| UCC1118 | MATα hhf1-hht1::LEU2 hhf2-hht2::MET15/pRM200U (URA3 CEN ARS)-HHF2-HHT2 | D. Gottschling |
| UCC6584 | MATα hhf1-hht1::LEU2 hhf2-hht2::MET15 ADE2-VR/pRM200U (URA3 CEN ARS)-HHF2-HHT2 | D. Gottschling |
| MPY201 | MATα hhf1-hht1::HIS3 hhf2-hht2::MET15 ADE2-VR/pRM200U (URA3 CEN ARS)-HHF2-HHT2 | This work |
| MPY202 | MATα hhf1-hht1::HIS3 hhf2-hht2::MET15 ADE2-VR Hat1::LYS2/pRM200U (URA3 CEN ARS)-HHF2-HHT2 | This work |
| UCC1111 | MATα adh4::URA3-TEL (VII-L) hhf1-hht1::LEU2 hhf2-hht2::MET15/pRS412 (ADE2 CEN ARS)-HHF2-HHT2 | 28 |
| MPY1 | MATα adh4::URA3-TEL (VII-L) hhf1-hht1::LEU2 hhf2-hht2::MET15 hat1::HIS3/pRS412 (ADE2 CEN ARS)-HHF2-HHT2 | 28 |
| SQY101 | MATα adh4::URA3-TEL (VII-L) hhf1-hht1::LEU2 hhf2-hht2::MET15 rad52::HIS3/pRS412 (ADE2 CEN ARS)-HHF2-HHT2 | This work |
| SQY105 | MATα adh4::URA3-TEL (VII-L) hhf1-hht1::LEU2 hhf2-hht2::MET15 yku70::HIS3/pRS412 (ADE2 CEN ARS)-HHF2-HHT2 | This work |
| TKY109 | MATα adh4::URA3-TEL (VII-L) hhf1-hht1::LEU2 hhf2-hht2::MET15 cac1::HIS3 | This work |
| TKY114 | MATα adh4::URA3-TEL (VII-L) hhf1-hht1::LEU2 hhf2-hht2::MET15 cac1::HIS3 hat1::LYS2 | This work |
| SQY114 | MATα adh4::URA3-TEL (VII-L) hhf1-hht1::LEU2 hhf2-hht2::MET15 asf1::HIS3 | This work |
| SQY126 | MATα adh4::URA3-TEL (VII-L) hhf1-hht1::LEU2 hhf2-hht2::MET15 asf1::HIS3 hat1::LYS2 | This work |
| SQY317 | MATa hhf1-hht1::LEU2 hhf2-hht2::MET15 sml1::URA3 rad53::HIS3 | This work |
All strains were originally derived from BY4704 or BY4705 and have the genotype ade2::hisG his3Δ200 leu2Δ0 lys2Δ0 met15Δ0 trp1Δ63 ura3Δ0.
The YKU70, CAC1, ASF1, and RAD52 genes were deleted in UCC1111 by PCR-mediated gene disruption with HIS3 to generate SQY105, TKY109, SQY114, and SQY101, respectively. The hat1::LYS2 allele was then introduced into TKY109 and SQY114 to generate TKY114 and SQY126, respectively. A rad53Δ strain was constructed by first deleting the SML1 gene by PCR-mediated gene disruption with URA3 in strain MPY302 [MATa ade2Δ::hisG his3Δ200 leu2Δ0 lys2Δ0 met15Δ0 Δhhf2-hht2::MET15 Δhhf1-hht1::LEU2/pRS412 (ADE2 CEN ARS)-HHF2-HHT2]. A rad53Δ mutation was then introduced by PCR-mediated gene disruption with the HIS3 gene. Southern blotting or PCR was used to confirm all genetic deletions.
Flow cytometry.
Cultures (50 ml) were grown to mid-log phase and then split, with methyl methanesulfonate (MMS) (0.03%) added to one culture. Aliquots were harvested from each culture at designated time points and washed twice with cold water. Then 107 cells were fixed overnight in 70% ethanol. Cells were then washed with 50 mM sodium citrate (pH 7.5) and resuspended in 950 μl of 50 mM sodium citrate; 50 μl of 5-mg/ml RNase A was added, and the samples were incubated at 50°C for 1 h. Then 50 μl of 20-mg/ml proteinase K was added, and the incubation was continued for 1 h at 50°C. The cells were transferred to plastic tubes (12 mm by 75 mm), and 20 μl of SYBR Green I (Molecular Probes) working solution (1:10 dilution of the commercial stock solution) was added. Samples were incubated at 4°C overnight protected from light. Then 2.5 μl of Triton X-100 was added, and each sample was vortexed and subsequently sonicated for 15 s; 20,000 cells for each sample were analyzed on a Beckman Coulter Elite flow cytometer.
DNA damage assays. (i) MMS sensitivity.
Individual colonies of similar size were picked from yeast extract-peptone-dextrose (YPD) plates and suspended in 200 μl of distilled water. Tenfold serial dilutions of the cell suspensions were made, and 10 μl of each dilution was spotted onto synthetic complete plates (HC) containing the indicated concentrations of MMS. The plates were incubated for 3 to 5 days at 30°C and then photographed. At least three individual colonies of each yeast strain were tested, with a representative set shown in the figures.
(ii) UV sensitivity.
Serial dilutions of cells made as described above were spotted onto HC plates and exposed to the indicated doses of UV irradiation in a UV Stratalinker (Stratagene). The plates were then incubated in the dark at 30°C for 3 days. The viability of each strain was determined as the ratio of colonies formed on the UV-irradiated plates to those formed on plates not exposed to UV.
(iii) Endonuclease sensitivity.
Cells containing YCpGal:R1b, a plasmid that encodes a galactose-inducible EcoRI endonuclease, were grown overnight in liquid synthetic complete medium lacking uracil (5). Equal numbers of cells were plated onto HC plates lacking uracil and containing either 2% glucose (HC-Ura) or 3% galactose (Gal-Ura). After 7 to 10 days of incubation at 30°C, the number of colonies formed on Gal-Ura plates and HC-Ura plates was determined. Tenfold serial dilutions of yeast strains containing the pGAL-HO-pRS412 plasmid were spotted onto HC plates without adenine and containing either 2% glucose (HC-Ade) or 3% galactose (Gal-Ade). The plates were then incubated at 30°C for 3 to 5 days and photographed.
Linear plasmid transformation efficiency assay.
pRS412 was linearized with EcoRI or BamHI overnight at 37°C and then purified by agarose gel electrophoresis. Either linear or circular plasmid DNA (20 ng) was transformed into the indicated yeast strains and plated onto HC-Ade plates. After incubation at 30°C for 5 to 7 days, the ratio of colonies formed by linear plasmid transformation to colonies formed by circular plasmid transformation was determined.
Physical monitoring of recombinational repair.
Analysis of the repair of HO-induced double-strand breaks was performed essentially as described previously (21). Briefly, cells transformed with pGALHO-pRS412 were inoculated into 5-ml YPD cultures. These were then used to inoculate 200-ml cultures of YP medium containing 3% lactic acid. Cells were grown to mid-log phase at 30°C, and 15 ml was removed as the uninduced sample. Galactose was then added to a final concentration of 2%, and the cultures were incubated at 30°C for additional 1 h to induce HO endonuclease expression. An aliquot was taken (induced), and the cells were harvested, washed once with sterile water, and then resuspended in 200 ml of fresh YPD medium. Aliquots were taken at designated time points, and genomic DNA was purified.
DNA concentrations were measured, and an appropriate volume of each DNA solution was cut with StyI at 37°C overnight. Southern blotting was performed as described in the Boehringer Mannheim nonradioactive DNA labeling and detection kit with minor modifications, in which CDP-star was used to generate luminescent signals that were visualized on standard X-ray film. For quantitation, the ECF signal amplification kit (Amersham Pharmacia) was used to detect the nucleic acid signals by scanning on a Storm phosphoimager. The intensity of DNA bands was calculated with ImageQuant 5 software. The ratio of the intensity of the MATa band relative to the MAT-distal band was determined for each time point.
Telomeric silencing assays.
Telomeric silencing was measured as described previously (28).
RESULTS
Histone H3 lysine residues 14 and 23 are important for DNA damage repair.
Five lysine residues (at positions 9, 14, 18, 23, and 27) in the histone H3 NH2-terminal tail are subject to reversible acetylation. To determine whether these residues are important for the repair of DNA damage, we introduced into S. cerevisiae, as the sole copy of histone H3 (HHT2), an allele encoding a protein in which all five lysines were converted to arginine. The lysine residues were changed to arginine to mimic the constitutively unacetylated state of the histone H3 NH2-terminal tail. This allele dramatically reduced the viability of cells grown in the presence of the DNA-damaging agent MMS, indicating that the acetylatable lysine residues of the histone H3 NH2-terminal tail are important for the repair of damaged DNA (Fig. 1A).
FIG. 1.
Analysis of the role of histone H3 NH2-terminal tail lysine residues in DNA damage repair. The indicated histone H3 alleles in which either four to five (A) or two (B) lysines have been changed to arginine were introduced on plasmids into strain UCC1111 (wild type [WT]). Sensitivity to DNA damage was measured by spotting 10-fold serial dilutions of cells on synthetic complete plates (HC) or synthetic complete plates containing the indicated concentration of MMS (Materials and Methods). Plates were photographed after 3 to 5 days of growth at 30°C. (C) The indicated histone H3 alleles were transformed into strain UCC1111 (wild type). DNA damage sensitivity was measured as above, and telomeric silencing was assayed by spotting cells on synthetic complete plates containing 5-fluoroorotic acid (5-FOA).
The contribution of each of the five lysine residues to the process of DNA damage repair was then evaluated. We measured the MMS sensitivity of cells with histone H3 alleles in which all combinations of four of the five lysine residues were converted to arginine (Fig. 1A). When a single lysine residue was present at position 9, 18, or 27, there was little change in MMS sensitivity compared to the quintuple lysine-to-arginine allele. However, the presence of a single lysine residue at either position 14 or 23 was sufficient to restore DNA damage repair to nearly wild-type levels.
The importance of histone H3 lysine residues 14 and 23 in DNA damage repair was confirmed by comparing the MMS sensitivities of a set of histone H3 alleles comprising all possible combinations of changing two of the five lysine residues to arginine (Fig. 1B). While most of the histone H3 double mutations caused little increase in sensitivity to MMS, changing both lysines 14 and 23 to arginine increased the sensitivity to MMS by 1,000-fold. Taken together, these results suggest that specific lysines in the histone H3 NH2-terminal tail, namely residues 14 and 23, play a critical role, either directly or indirectly, in DNA damage repair. In addition, these residues appear to function redundantly, as the presence of a single lysine residue at either position 14 or 23 was sufficient to enable the repair of damaged DNA (Fig. 1A).
The DNA damage sensitivity of the histone H3 K14,23R mutant may be the result of interference with an essential modification (such as acetylation) that occurs at these sites or may reflect a specific structural requirement for a lysine residue at these positions. In an effort to distinguish between these possibilities, we looked at the DNA damage sensitivity of a mutant in which lysine residues 14 and 23 were changed to glutamine. We chose glutamine because it is a neutral amino acid that is structurally most similar to acetyllysine. If the acetylation of lysines 14 and 23 is important for DNA damage repair, we predicted that the H3 K14,23Q mutant would be less sensitive to DNA-damaging agents than the H3 K14,23R mutant. As shown in Fig. 1C, this prediction was confirmed. However, while the H3 K14,23Q mutant was significantly less sensitive to MMS than the H3 K14,23R mutant, DNA damage repair was not restored to wild-type levels, perhaps reflecting the inability of glutamine to completely mimic acetyllysine.
The pattern of lysine residues in the histone H3 NH2-terminal tail that is required for DNA damage repair is similar to the pattern required for the formation of telomeric chromatin structure, in which lysines 14 and 23 also play a dominant role (28). While cells carrying the H3 K14,23Q allele exhibited improved DNA damage repair relative to cells carrying the H3 K14,23R allele, these alleles had opposite effects on telomeric silencing. Where the H3 K14,23R allele supported a moderate level of telomeric silencing, the H3 K14,23Q allele completely eliminated it (Fig. 1C). Therefore, histone H3 lysines 14 and 23 perform distinct functions in DNA damage repair and telomeric silencing, as observed from the differences between the arginine and glutamine substitutions.
Mutations in HAT1 and specific lysine residues in the histone H3 NH2-terminal tail confer sensitivity to DNA damage.
We have recently shown that Hat1p and specific histone H3 lysine residues are redundantly required for telomeric silencing (28). While Hat1p is primarily redundant with histone H3 lysine 14, the reduction of telomeric silencing is greater if at least one other residue is mutated. For example, combining mutations in HAT1 with an H3 K9,14R, H3 K14,23R, or H3 K14,27R allele resulted in a 100-fold decrease in telomeric silencing. To determine whether Hat1p plays a related role in DNA damage repair, we tested whether the same mutant combinations resulted in an increased sensitivity to MMS. Surprisingly, we did not observe any HAT1-dependent increases in MMS sensitivity with any of the histone H3 alleles that generated defects in telomeric silencing (data not shown).
Cells carrying a hat1Δ and a wild-type histone H3 allele also were not sensitive to MMS-induced DNA damage. A hat1Δ allele was then combined with a complete set of histone H3 alleles in which the five acetylatable lysine residues had been converted to arginine in every possible permutation. This analysis identified one allele, H3 K9,18,27R, that generated a synthetic MMS sensitivity when combined with hat1Δ. This combination resulted in a 10- to 100-fold increase in sensitivity to MMS (Fig. 2A). Therefore, while Hat1p appears to function in both DNA damage repair and telomeric chromatin formation, its role in these processes is functionally redundant with different sets of lysine residues in the histone H3 NH2-terminal tail.
FIG. 2.
Mutations in HAT1 and specific lysine residues in histone H3 confer sensitivity to DNA-damaging agents. (A) The indicated histone H3 allele was introduced into strains UCC1111 (wild type [WT]) and MPY1 (hat1Δ). DNA damage sensitivity was assayed as described for Fig. 1. (B) The indicated histone H3 alleles were introduced in strains UCC1111 (wild type), MPY1 (hat1Δ), and SQY101 (rad52Δ) and tested for sensitivity to MMS as described for Fig. 1.
MMS is an alkylating agent that causes single-strand DNA damage at low concentrations. At high concentrations, the proximity of the sites of single-strand damage results in the formation of DNA double-strand breaks (30a, 48a). The histone H3 and hat1Δ mutations are sensitive to relatively high concentrations of MMS. To determine how these phenotypes compare to those of a well-characterized DNA repair mutant, we compared the MMS sensitivity of the histone H3 and hat1Δ mutants to that of a rad52Δ mutant (Fig. 2B). The viability of a rad52Δ mutant began to decrease at a concentration of 0.005% MMS, whereas the phenotypes of the histone H3 and hat1Δ mutants were manifest at MMS concentrations of 0.03% and 0.04%, respectively. This level of MMS sensitivity is similar to that seen for mutations in other chromatin-related proteins in S. cerevisiae that influence DNA repair, such as Ino80p and histone H2A (11, 49). These results suggest that while mutations affecting chromatin structure clearly impact DNA repair, they do not completely block the repair process.
Mutations in histone H3 and HAT1 specifically cause sensitivity to DNA double-strand breaks.
We have identified two sets of mutations that confer sensitivity to MMS-induced DNA damage, H3 K14,23R and hat1Δ H3 K9,18,27R. As MMS can cause both single- and double-strand DNA damage, we were interested in more specifically determining the types of DNA damage to which these mutants were sensitive. We tested whether any of the histone H3 HAT1 mutants exhibited an increase in sensitivity to UV radiation, which causes single- strand DNA damage that is primarily reversed via nucleotide excision repair. From Fig. 3A, it is clear that the response of the H3 K14,23R and hat1Δ H3 K9,18,27R mutants to increasing doses of UV radiation was indistinguishable from that of the wild-type strain.
FIG. 3.
HAT1 and histone H3 mutants are specifically sensitive to DNA double-strand breaks. The indicated histone H3 alleles were introduced into strains UCC1111 (wild type [WT]) and MPY1 (hat1Δ). (A) Sensitivity of each strain to UV irradiation was measured as described in Materials and Methods. Each mutant combination was analyzed three to five times, with no increase in UV sensitivity detected. A representative example is shown. (B) Strains MPY201 (wild type) and MPY202 (hat1Δ) were transformed with a plasmid containing the indicated histone H3 allele and YCpGal:R1b (5). Sensitivity to galactose-induced expression of EcoRI was measured as described in Materials and Methods. The values given are the cumulative totals from six independent experiments.
To specifically address whether the histone H3/HAT1 mutants were sensitive to DNA double-strand breaks, we introduced into the cells a plasmid containing the EcoRI endonuclease driven from a galactose-inducible promoter. When these cells are grown on galactose, the induced EcoRI generates DNA double-strand breaks throughout the genome. The viability of neither the hat1Δ nor the H3 K9,18,27R mutants alone was significantly different from that of the wild-type strain following EcoRI induction, as indicated by growth on galactose-containing medium. However, the viability of cells containing either the H3 K14,23R or the hat1Δ H3 K9,18,27R mutations was reduced 20- to 50-fold by the induction of EcoRI (Fig. 3B). Thus, the MMS sensitivity conferred by these mutations is an indication of sensitivity to DNA double-strand breaks.
Mutations in histone H3 and HAT1 do not affect the cell cycle response to DNA damage.
Damage to eukaryotic DNA activates checkpoint pathways that arrest the cell cycle, allowing time for repair (40, 43, 61). A link between DNA damage checkpoints and chromatin assembly has been drawn from the identification of a physical interaction between the DNA damage checkpoint kinase Rad53p and the chromatin assembly factor Asf1p (14, 22). This raises the possibility that mutations in histone H3 and HAT1 may affect some aspect of the signal transduction pathways that control the DNA damage checkpoints. Therefore, the histone H3 and HAT1 mutants that we have identified may have decreased viability in the presence of DNA double-strand breaks due to defects in the normal cell cycle response to DNA damage.
To test the possibility that histone H3 and HAT1 influence DNA damage checkpoints, we examined the cell cycle response of liquid cultures to DNA damage. Cultures were grown to mid-log phase and then divided in two, with one culture treated with MMS (0.03%) and the other left untreated. Cells were harvested periodically, and the cell cycle distribution of the cultures was determined by flow cytometry (Fig. 4). Our wild-type strain exhibited the characteristic cell cycle response to DNA damage (Fig. 4, far left) (43). There was a rapid accumulation of cells with an S-phase DNA content. These cells then appeared to proceed slowly through S phase and into G2 over several hours. By contrast, the cell cycle distribution of a strain lacking Rad53p (in an sml1Δ background) was only subtly altered by the presence of DNA damage. There was no accumulation of cells in S phase and only a minor increase in cells with a G2 DNA content, indicative of the residual Chk1p-dependent G2/M checkpoint (Fig. 4, far right). Both the H3 K14,23R and the hat1Δ H3 K9,18,27R mutants displayed a cell cycle response to DNA damage that was indistinguishable from that of the wild-type strain (Fig. 4, middle). This indicates that these mutations in histone H3 and HAT1 do not significantly affect the DNA damage checkpoint pathways.
FIG. 4.
Mutations in histone H3 and HAT1 do not affect the cell cycle response to DNA damage. Liquid cultures of the indicated strains were grown to log phase in the absence or presence of MMS (0.03%). Cells were harvested at the indicated time points, fixed, and stained with the DNA-specific dye SYBR Green. The cell cycle distribution of the culture was determined by flow cytometry. WT, wild type.
Histone H3 and HAT1 mutants are primarily defective in the recombinational repair of DNA double-strand breaks.
The absence of DNA damage checkpoint defects in the histone H3 and HAT1 mutants suggests that these factors may be more directly involved in the DNA repair process. DNA double-strand breaks in eukaryotes are repaired by two main pathways, nonhomologous end joining (NHEJ) and homologous recombination. The relative efficiency with which a strain can be transformed with a linearized plasmid is indicative of the degree to which the NHEJ pathway is capable of recircularizing the plasmid (33).
Figure 5A shows the relative linear transformation efficiencies of various strains, with the value of the wild-type strain set to 100%. No decrease in linear plasmid transformation efficiency was associated with either the hat1Δ, the H3 K9,18,27R, or the hat1Δ H3 K9,18,27R mutations. However, there was a small but reproducible effect of the H3 K14,23R mutation on NHEJ, where the linear plasmid transformation efficiency dropped to approximately 60% of the wild-type value. By comparison, deletion of the yeast Ku70 homolog YKU70 reduced NHEJ 10-fold.
FIG. 5.
Histone H3 and HAT1 mutants are primarily defective in the recombinational repair of DNA double-strand breaks. (A) Strains UCC1111 (wild type [WT]), MPY1 (hat1Δ), and SQY105 (yku70Δ) were combined with the indicated histone H3 allele. The viability of each strain after transformation with a linearized form of pRS412 was measured as described in Materials and Methods. The bars represent the means of four to six independent trials, with the error bars indicating the standard errors. The linear plasmid transformation efficiency of the wild-type strain was designated 100%. (B) UCC1111 (wild type) and MPY1 (hat1Δ), containing the indicated histone H3 alleles, were transformed with pGALHO-pRS412 (Materials and Methods). Sensitivity to the HO endonuclease was determined by spotting 10-fold serial dilutions of cells on synthetic complete plates lacking adenine and containing either glucose (-ADE) or galactose (-ADE,GAL) as the sole carbon source. Plates were photographed after 3 to 5 days of growth at 30°C.
The yeast mating type switching system can be used to study the recombinational repair of DNA double-strand breaks. The endonuclease HO creates a single double-strand break in the yeast genome at the MAT locus. This double-strand break is normally repaired by Rad52p-dependent homologous recombination with either of the silent mating loci, HML or HMR, as the source of homologous sequence (19). We transformed into our strains an ADE2-based vector containing a galactose-inducible HO gene (a generous gift of M. DuBois). The ability of cells containing the histone H3 and HAT1 mutations to grow on medium containing galactose (which induces production of the HO endonuclease) was then used as an indication of the proficiency with which these strains can repair a DNA double-strand break by homologous recombination.
Wild-type cells grew equally well on medium containing either glucose or galactose, indicating that they efficiently repaired an HO-induced DNA double-strand break (Fig. 5B). Consistent with previous reports, introduction of a rad52Δ mutation resulted in a roughly 1,000-fold decrease in viability following HO induction (Fig. 5B) (40a, 40b, 60a). The H3 K14,23R mutant demonstrated a high degree of sensitivity to HO induction. When these cells were plated onto galactose-containing medium, there was a 10- to 100-fold decrease in the number of colonies formed (Fig. 5B). In addition, the colonies formed by the H3 K14,23R cells were small and red. A red colony color is indicative of Ade− cells, suggesting that, even though selection for the ADE2-based Gal-HO vector was maintained during growth on galactose, the plasmid was unstable in this mutant. Indeed, we found that while the Gal-HO plasmid was stable in wild-type cells, it was lost in 90% of the H3 K14,23R cells during growth on galactose (data not shown). Importantly, combining hat1Δ with the H3 K14,23R allele resulted in a further 10-fold decrease in both colony number and plasmid stability, suggesting that these factors have nonoverlapping functions in DNA damage repair that were not evident with less-specific assays (Fig. 5B and data not shown).
As expected, induction of the HO gene resulted in little, if any, change in the growth of cells containing either a hat1Δ or the H3 K9,18,27R allele (Fig. 5B). However, the hat1Δ H3 K9,18,27R mutant was sensitive to HO induction. When grown on galactose-containing medium, the colony size of the double mutant was dramatically reduced (Fig. 5B). In addition, the colonies also developed a red color. As seen for the H3 K14,23R mutants, this change in colony color reflected an instability of the Gal-HO plasmid, being lost in 90% of the hat1Δ H3 K9,18,27R cells during growth on galactose (data not shown). It should be noted that all of the mutants grew normally on galactose when the HO gene was deleted from the Gal-HO plasmid (leaving the GAL promoter intact), indicating that the growth defects observed in Fig. 5B were dependent on the HO endonuclease (data not shown). Therefore, the hat1Δ H3 K9,18,27R mutants are clearly sensitive to the introduction of a single HO-mediated double-strand break in the MAT locus.
Interpretation of the experiment presented in Fig. 5B was complicated by the fact that the cells growing on galactose were continuously exposed to the HO endonuclease over many generations. To obtain direct evidence that the phenotype of the H3 K14,23R and hat1Δ H3 K9,18,27R mutants was a reflection of defects in the recombinational repair process, we took advantage of the “in vivo biochemistry” methodologies developed in the Haber laboratory to physically monitor the recombinational repair of HO-induced double-strand breaks (18, 21, 63). Briefly, mid-log-phase liquid cultures are exposed to a brief (1-h) pulse of HO endonuclease. Expression of HO is then repressed, and cells are harvested at various time points for the analysis of genomic DNA. Taking advantage of restriction site patterns specific to MATa and MATα, Southern blots are used to monitor the mating type conversion that results from the recombinational repair of the HO-induced double-strand break (depicted schematically in Fig. 6A).
FIG. 6.
Histone H3 and HAT1 mutants are defective in the repair of an HO-induced DNA double-strand break at the MAT locus. (A) Schematic representation showing the conversion of a strain from MATα to MATa. The positions of the relevant HO and StyI endonuclease sites are shown. The probe used to monitor MAT switching on Southern blots is indicated by the labeled bar, and the restriction fragments that are visualized are shown along the bottom. Diagram is not drawn to scale. (B to H) Strains UCC1111 (wild type [WT]) and MPY1 (hat1Δ) were combined with the indicated histone H3 allele and transformed with a plasmid encoding a galactose-inducible HO gene (pGALHO-pRS412). Genomic DNA was isolated from uninduced cells (lanes U) and cells that had been grown in galactose for 1 h to induce expression of HO (lanes I). HO expression was then repressed by the addition of glucose, and genomic DNA was isolated from cells harvested at the indicated time points. Southern blots of StyI-digested genomic DNA were hybridized with the indicated probe. Arrows on the left of each blot indicate the identities of the visualized bands. (I) Duplicate blots were visualized with chemifluorescent probes and quantitated on a Storm imager with ImageQuant software. The ratio of the MATa fragment to the MAT-distal fragment was plotted versus time. The ratio of the HO-cut fragment to the MAT-distal fragment was similar for each strain.
Recombinational repair of an HO-induced double-strand break in a wild-type, MATα strain is shown in Fig. 6B and quantitated in Fig. 6I. Induction of HO was accompanied by the appearance of a small band resulting from HO cleavage of the MATα fragment. Within 30 min, robust repair was evident in the appearance of a band corresponding to the conversion to MATa. The level of the MATa band increased for 3 to 4 h before reaching a plateau. The involvement of the recombinational repair pathway in the generation of the MATa band was confirmed by the analysis of an isogenic rad52Δ mutant (Fig. 6C and I).
The presence of the H3 K14,23R allele (with and without hat1Δ) caused a clear defect in recombinational repair (Fig. 6D, E, and I). The appearance of the repaired MATa band was delayed, and its accumulation plateaued at much lower levels. For the H3 K9,18,27R and hat1Δ mutants, consistent with the absence of an HO-dependent growth defect, the level of recombinational repair in either of the single mutants was similar to that in the wild-type strain (Fig. 6F, G, and I). However, when these mutations were combined, we again saw a marked decrease in recombinational repair (Fig. 6H and I).
Importantly, quantitation of the HO cleavage fragment showed that that there was equal cutting of the MATα locus in all of the strains examined (see the legend to Fig. 6). It is likely that the cumulative effect of the decreased recombinational repair efficiency observed in the histone H3 and HAT1 mutants resulted in the growth defects seen in these strains during long-term exposure to HO expression. Taken together, these results indicate that mutations affecting both Hat1p and the acetylatable lysine residues in the histone H3 NH2-terminal tail compromise the recombinational repair of DNA double-strand breaks.
Histone H3 and Hat1p may influence DNA damage repair through an Asf1p-dependent mechanism.
DNA synthesis is a requisite step in the recombinational repair of DNA double-strand breaks. The assembly of this newly synthesized DNA into chromatin is one step in the recombinational repair pathway that may be influenced by mutations in histone H3 and HAT1. To determine whether histone H3 and Hat1p function in chromatin assembly during recombinational repair, we tested whether mutations eliminating the yeast CAF-1 and RCAF chromatin assembly activities affected the DNA damage sensitivity of the histone H3 and HAT1 mutants.
As shown in Fig. 7, deletion of the CAC1 gene, encoding the largest subunit of the yeast CAF-1 complex, had no effect on the viability of cells following the induction of HO endonuclease. In addition, the cac1Δ mutation did not affect the HO sensitivity of the H3 K14,23R and hat1Δ H3 K9,18,27R mutants. These results indicate that the yeast CAF-1 complex is not required for the recombinational repair of DNA double-strand breaks and that histone H3 and Hat1p are not influencing recombinational repair through CAF-1-dependent chromatin assembly.
FIG. 7.
Effects of histone H3 and HAT1 mutations on DNA repair are independent of CAC1. The indicated histone H3 alleles were transformed into UCC1111 (wild type [WT]), TKY109 (cac1Δ), and TKY114 (cac1Δ hat1Δ). Sensitivity to HO endonuclease was determined as described for Fig. 4.
A very different result was obtained in the absence of the yeast RCAF activity Asf1p. An asf1Δ strain containing a galactose-inducible HO gene was unable to grow on galactose-containing medium (Fig. 8A). To determine whether this growth defect resulted from an inability to repair an HO-induced DNA double-strand break, we physically monitored the fate of the HO-cleaved MAT locus. As shown in Fig. 8B and C, the level of recombinational repair was reduced to levels approaching those of a rad52Δ mutant, indicating that Asf1p is required for the efficient repair of DNA double-strand breaks.
FIG. 8.
Histone H3 and HAT1 mutations do not increase the DNA damage sensitivity of cells lacking the chromatin assembly factor gene ASF1. The indicated histone H3 alleles were transformed into UCC1111 (wild type [WT]), SQY114 (asf1Δ), and SQY126 (asf1Δ hat1Δ). (A) Sensitivity to HO endonuclease was determined as described for Fig. 4. (B) Repair of an HO-mediated double-strand break at the MAT locus in SQY114 (asf1Δ) was physically monitored as described for Fig. 6. (C) A duplicated blot was quantitated by chemifluoresence as described for Fig. 6. The data for the wild-type strain (UCC1111) and a rad52Δ strain (SQY101) from Fig. 6I are shown for reference. (D) Sensitivity of the strains in panel A to the indicated concentrations of MMS was determined as described for Fig. 1.
The poor growth of asf1Δ cells following induction of the HO endonuclease made it impossible to reliably determine whether histone H3 and Hat1p function through Asf1p in recombinational repair in the HO sensitivity assay. Therefore, we examined the epistasis relationships between ASF1, histone H3, and HAT1 by using sensitivity to MMS as an assay. As shown in Fig. 8D and also shown by others, an asf1Δ strain was sensitive to MMS (31, 56). Importantly, the H3 K14,23R and hat1Δ H3 K9,18,27R mutations did not cause a further increase in sensitivity to MMS (Fig. 8D). It should be noted that the inability of the histone H3 and HAT1 mutations to increase MMS sensitivity in the absence of Asf1p was not a consequence of the lower concentrations of MMS to which the asf1Δ strain is sensitive. An H3 K14,23R mutation can increase the MMS sensitivity of a rad52Δ strain that is sensitive to even lower concentrations of MMS, consistent with the effects of this allele on both NHEJ and recombinational repair (data not shown). Therefore, these results are consistent with the possibility that histone H3 and Hat1p may function in the recombinational repair of DNA double-strand breaks through an Asf1p-dependent mechanism.
DISCUSSION
The role of chromatin structural components and chromatin-modifying activities in the regulation of transcription has been extensively studied. While chromatin structure certainly impacts other cellular processes that involve chromosomal DNA, such as DNA replication, repair, and recombination, its role in these processes has not received similar attention. In this study, we have presented evidence that both specific lysine residues in the histone H3 NH2-terminal tail and the type B histone acetyltransferase Hat1p function in DNA damage repair.
Chromatin structure and DNA repair.
Several recent reports have also indicated a link between chromatin structure and DNA damage repair (16, 38). The core histone H2A (or the variant H2AX in mammalian cells) is phosphorylated in response to DNA double-strand breaks. In mammalian cells, this phosphorylation occurs rapidly and is localized to discreet foci near the sites of DNA damage (42, 46, 47). The histone H2A phosphorylation site is evolutionarily conserved and is contained within a consensus for phosphatidylinositol-3-OH kinase-related kinases (11, 47). Several members of this family of kinases play important roles in DNA repair, such as the human proteins DNA-PK, ATM, and ATR and the yeast proteins Mec1p and Tel1p (12). Confirming a role for this histone modification in DNA repair, mutating the histone H2A phosphorylation site in S. cerevisiae results in defects in the repair of DNA double-strand breaks (11).
In addition, a role for chromatin modification in DNA repair was suggested by the identification of eukaryotic homologues of the bacterial RuvB protein in the yeast Ino80p ATP-dependent chromatin remodeling complex and the human Tip60 histone acetyltransferase complex (23, 49). The bacterial RuvB protein is part of a complex involved in the branch migration of Holliday junctions during homologous recombination and the recombinational repair of DNA damage (62). Mutations affecting the Ino80p and Tip60 complexes display phenotypes consistent with a potential role in DNA damage repair. Ino80Δ yeast strains are sensitive to multiple DNA-damaging agents, while a human cell line transformed with a dominant negative Tip60 allele, lacking histone acetyltransferase activity, is defective in DNA double-strand break repair (23, 49).
There are a number of mechanisms through which chromatin modifications might impact the repair of damaged DNA. Specific chromatin modifications may be necessary for components of the DNA repair or checkpoint machinery to recognize damaged DNA in a chromatin context. A related possibility is that chromatin modifications may be required for generating an open chromatin structure that makes damaged DNA accessible to the repair machinery.
Chromatin modification activities may also function in the repackaging of DNA into chromatin following its repair. Alternatively, chromatin-modifying activities may influence DNA repair indirectly through controlling the expression of factors that are directly involved in repair. While the specific aspect of DNA repair influenced by histone H3 and Hat1p is not known, the decreased level of recombinational repair observed in the histone H3 and HAT1 mutants suggests the intriguing possibility that chromatin assembly may be integrated into the process of repair, so that efficient repair is coupled to the subsequent reformation of chromatin structure.
Histone acetylation and chromatin assembly.
While the cycle of acetylation and deacetylation that occurs on the NH2-terminal tails of newly synthesized histones H3 and H4 closely correlates with the process of chromatin assembly, there is little evidence directly linking these phenomena. Several potential sources of functional redundancy inherent in the process of chromatin assembly likely complicate the assignment of an in vivo function to the acetylation of newly synthesized histones (36). Eliminating potential redundancy between the acetylation of histones H3 and H4 by combining mutations in HAT1 and the acetylatable lysine residues in the histone H3 NH2-terminal tail has allowed us to begin to link histone acetylation and chromatin assembly in vivo.
While neither CAF-1 nor Asf1p activity is essential for viability, yeast cells lacking these factors display phenotypes that are suggestive of defects in cellular processes that are likely to be influenced by alterations in chromatin assembly. For example, both CAF-1 and Asf1p have been linked to the formation of silent chromatin structure and DNA repair. The observation that combining mutations in HAT1 and histone H3 also results in defects in telomeric silencing and DNA repair is consistent with the acetylation of newly synthesized histones playing a role in chromatin assembly. In addition, the genetic relationships between ASF1, HAT1, and histone H3 identified in the present study are consistent with the possibility that histone acetylation plays a role in Asf1p-dependent chromatin assembly. Significantly, yeast Asf1p and acetylated histones H3 and H4 have been found to be physically associated with the DNA damage checkpoint kinase Rad53p (14, 22). The sites of acetylation on the histones associated with the Rad53p-Asf1p complex have not been mapped. It will be interesting to determine whether they are related to the mutations in histone H3 and HAT1 characterized here.
The ability to detect defects in specific cellular processes in histone H3/HAT1 mutants without observing general growth defects suggests that multiple pathways for chromatin assembly are active in the cell and that some pathways may not require the acetylation of newly synthesized histones. Consistent with this idea, the absence of a defect in nucleotide excision repair in any of the histone H3 or HAT1 mutants is compatible with recent results indicating that the interaction between CAF-1 and histones H3 and H4 occurs independently of the NH2-terminal tails (50). These results suggest that there may be distinct pathways for the assembly of chromatin associated with different modes of DNA repair.
Histone H3 and NHEJ.
The repair of DNA double-strand breaks by NHEJ does not involve extensive new DNA synthesis and is therefore unlikely to require chromatin assembly. However, the histone H3 K14,23R allele caused a partial reduction in NHEJ, as measured by the recircularization of a linearized plasmid. One potential role for histone H3 lysine residues 14 and 23 in NHEJ is suggested by the recent report that the core histone tails can play an important role in modulating the activity of DNA ligase when it is acting on chromatin templates (9). Alternatively, the histone H3 tail may be important for generating a chromatin structure that allows other components of the NHEJ pathway to recognize or associate with a broken DNA end.
The histone H3 NH2-terminal tail may also be indirectly impacting the NHEJ process. Several proteins essential for yeast silent chromatin formation, Sir2p, Sir3p, and Sir4p, have been reported to play a role in NHEJ (55). Rather than being directly involved in NHEJ, the repair defect in strains lacking these proteins is primarily the result of inappropriate expression of the silent mating loci (32). However, this mechanism is unlikely to apply to the H3 K14,23R mutant, as altering the lysine residues in the histone H3 NH2-terminal tail does not cause derepression of the HMR locus (28). In addition, quantitative mating assays demonstrate that the histone H3 and hat1Δ mutants characterized in the present study did not display a significant reduction in mating efficiency (data not shown).
Telomeric chromatin and DNA repair.
While an assessment of the roles of histone H3 and Hat1p in DNA damage repair was prompted in part by the emerging link between the maintenance of telomeres and DNA repair, several lines of evidence suggest that they play distinct roles in the two processes. First, while histone H3 lysines 14 and 23 play important roles in both telomeric silencing and DNA damage repair, these processes are affected in opposite ways by the H3 K14,23R and H3 K14,23Q alleles. Second, the roles of Hat1p in telomeric silencing and DNA repair are functionally redundant with different patterns of lysine residues in the histone H3 NH2-terminal tail. The observation that Hat1p can be functionally redundant with different sets of histone H3 lysine residues may indicate that chromatin assembly pathways with distinct acetylation pattern requirements function at specific chromatin domains (such as near telomeres) or in association with specific cellular processes (i.e., DNA replication or DNA repair). Also, the fact that mutations in all five of the lysines in the histone H3 NH2-terminal tail have been genetically linked to Hat1p is consistent with pulse-labeling experiments showing that each of these residues is acetylated, to some degree, in the pool of newly synthesized yeast histone H3 (30).
In summary, we have demonstrated that a structural component of chromatin (the lysine residues of the histone H3 NH2-terminal tail) and a histone-modifying enzyme (the type B histone acetyltransferase Hat1p) are specifically involved in the recombinational repair of DNA double-strand breaks. Genetic evidence also suggests that Hat1p and histone H3 influence recombinational repair through Asf1p-dependent chromatin assembly. The identification of yeast mutations that link chromatin structure and DNA repair will be valuable tools in the effort to decipher the mechanisms by which eukaryotic cells maintain genomic integrity.
Acknowledgments
We thank Tamara Kelly and Ericka Eugenie for help in the construction of strains and plasmids; R. Mann, M. Grunstein, and J. Rine for plasmids; and M. DuBois and D. Gottschling for generously providing yeast strains and plasmids prior to publication. We also thank A. Sklenar and M. DuBois and A. Annunziato for critical reading of the manuscript.
This work was supported by a seed grant from the American Cancer Society (Ohio Division), Research Project grant RPG-00-340-01-CSM from the American Cancer Society, and the National Institutes of Health (GM62970-01).
REFERENCES
- 1.Adams, A., D. E. Gottschling, C. A. Kaiser, and T. Stearns. 1997. Methods in yeast genetics. Cold Spring Harbor Laboratory Press, Cold Spring Harbor, N.Y.
- 2.Adams, C. R., and R. T. Kamakaka. 1999. Chromatin assembly: biochemical identities and genetic redundancy. Curr. Opin. Genet. Dev. 9:185-190. [DOI] [PubMed] [Google Scholar]
- 3.Annunziato, A. T., and J. C. Hansen. 2000. Role of histone acetylation in the assembly and modulation of chromatin structures. Gene. Expr. 9:37-61. [DOI] [PMC free article] [PubMed] [Google Scholar]
- 4.Annunziato, A. T., and R. L. Seale. 1983. Histone deacetylation is required for the maturation of newly replicated chromatin. J. Biol. Chem. 258:12675-12684. [PubMed] [Google Scholar]
- 5.Barnes, G., and J. Rine. 1985. Regulated expression of endonuclease EcoRI in Saccharomyces cerevisiae: nuclear entry and biological consequences. Proc. Natl. Acad. Sci. USA 82:1354-1358. [DOI] [PMC free article] [PubMed] [Google Scholar]
- 6.Bertuch, A., and V. Lundblad. 1998. Telomeres and double-strand breaks: trying to make ends meet. Trends Cell Biol. 8:339-342. [DOI] [PubMed] [Google Scholar]
- 7.Brachmann, C. B., A. Davies, G. J. Cost, E. Caputo, J. Li, P. Hieter, and J. D. Boeke. 1998. Designer deletion strains derived from Saccharomyces cerevisiae S288C: a useful set of strains and plasmids for PCR-mediated gene disruption and other applications. Yeast 14:115-132. [DOI] [PubMed] [Google Scholar]
- 8.Brown, C. E., T. Lechner, L. Howe, and J. L. Workman. 2000. The many HATs of transcription coactivators. Trends Biochem. Sci. 25:15-19. [DOI] [PubMed] [Google Scholar]
- 9.Chafin, D. R., J. M. Vitolo, L. A. Henricksen, R. A. Bambara, and J. J. Hayes. 2000. Human DNA ligase I efficiently seals nicks in nucleosomes. EMBO J. 19:5492-5501. [DOI] [PMC free article] [PubMed] [Google Scholar]
- 10.Chicoine, L. G., I. G. Schulman, R. Richman, R. G. Cook, and C. D. Allis. 1986. Nonrandom utilization of acetylation sites in histones isolated from Tetrahymena. Evidence for functionally distinct H4 acetylation sites. J. Biol. Chem. 261:1071-1076. [PubMed] [Google Scholar]
- 11.Downs, J. A., N. F. Lowndes, and S. P. Jackson. 2000. A role for Saccharomyces cerevisiae histone H2A in DNA repair. Nature 408:1001-1004. [DOI] [PubMed] [Google Scholar]
- 12.Durocher, D., and S. P. Jackson. 2001. DNA-PK, ATM and ATR as sensors of DNA damage: variations on a theme? Curr. Opin. Cell Biol. 13:225-231. [DOI] [PubMed] [Google Scholar]
- 13.Eberharter, A., T. Lechner, M. Goralik-Schramel, and P. Loidl. 1996. Purification and characterization of the cytoplasmic histone acetyltransferase B of maize embryos. FEBS Lett. 386:75-81. [DOI] [PubMed] [Google Scholar]
- 14.Emili, A., D. M. Schieltz, J. R. Yates 3rd, and L. H. Hartwell. 2001. Dynamic interaction of DNA damage checkpoint protein Rad53 with chromatin assembly factor Asf1. Mol. Cell 7:13-20. [DOI] [PubMed] [Google Scholar]
- 15.Grant, P. A., and S. L. Berger. 1999. Histone acetyltransferase complexes. Semin. Cell Dev. Biol. 10:169-177. [DOI] [PubMed] [Google Scholar]
- 16.Green, C. M., and G. Almouzni. 2002. When repair meets chromatin: first in series on chromatin dynamics. EMBO Rep. 3:28-33. [DOI] [PMC free article] [PubMed] [Google Scholar]
- 17.Guthrie, C., and G. R. Fink. 1991. Guide to yeast genetics and molecular biology. Academic Press, San Diego, Calif.
- 18.Haber, J. E. 1995. In vivo biochemistry: physical monitoring of recombination induced by site-specific endonucleases. Bioessays 17:609-620. [DOI] [PubMed] [Google Scholar]
- 19.Haber, J. E. 1998. Mating-type gene switching in Saccharomyces cerevisiae. Annu. Rev. Genet. 32:561-599. [DOI] [PubMed] [Google Scholar]
- 20.Herskowitz, I., and R. E. Jensen. 1991. Putting the HO gene to work: practical uses for mating type switching. Methods Enzymol. 194:132-146. [DOI] [PubMed] [Google Scholar]
- 21.Holmes, A., and J. E. Haber. 1999. Physical monitoring of HO-induced homologous recombination. Methods Mol. Biol. 113:403-415. [DOI] [PubMed] [Google Scholar]
- 22.Hu, F., A. A. Alcasabas, and S. J. Elledge. 2001. Asf1 links Rad53 to control of chromatin assembly. Genes Dev. 15:1061-1066. [DOI] [PMC free article] [PubMed] [Google Scholar]
- 23.Ikura, T., V. V. Ogryzko, M. Grigoriev, R. Groisman, J. Wang, M. Horikoshi, R. Scully, J. Qin, and Y. Nakatani. 2000. Involvement of the TIP60 histone acetylase complex in DNA repair and apoptosis. Cell 102:463-473. [DOI] [PubMed] [Google Scholar]
- 24.Imhof, A., and A. P. Wolffe. 1999. Purification and properties of the Xenopus hat1 acetyltransferase: association with the 14-3-3 proteins in the oocyte nucleus. Biochemistry 38:13085-13093. [DOI] [PubMed] [Google Scholar]
- 25.Jackson, V., A. Shires, N. Tanphaichitr, and R. Chalkley. 1976. Modifications to histones immediately after synthesis. J. Mol. Biol. 104:471-483. [DOI] [PubMed] [Google Scholar]
- 26.Kaufman, P. D., R. Kobayashi, N. Kessler, and B. Stillman. 1995. The p150 and p60 subunits of chromatin assembly factor I: a molecular link between newly synthesized histones and DNA replication. Cell 81:1105-1114. [DOI] [PubMed] [Google Scholar]
- 27.Kaufman, P. D., R. Kobayashi, and B. Stillman. 1997. Ultraviolet radiation sensitivity and reduction of telomeric silencing in Saccharomyces cerevisiae cells lacking chromatin assembly factor-I. Genes Dev. 11:345-357. [DOI] [PubMed] [Google Scholar]
- 28.Kelly, T. J., S. Qin, D. E. Gottschling, and M. R. Parthun. 2000. Type B histone acetyltransferase Hat1p participates in telomeric silencing. Mol. Cell. Biol. 20:7051-7058. [DOI] [PMC free article] [PubMed] [Google Scholar]
- 29.Kleff, S., E. D. Andrulis, C. W. Anderson, and R. Sternglanz. 1995. Identification of a gene encoding a yeast histone H4 acetyltransferase. J. Biol. Chem. 270:24674-24677. [DOI] [PubMed] [Google Scholar]
- 30.Kuo, M. H., J. E. Brownell, R. E. Sobel, T. A. Ranalli, R. G. Cook, D. G. Edmondson, S. Y. Roth, and C. D. Allis. 1996. Transcription-linked acetylation by Gcn5p of histones H3 and H4 at specific lysines. Nature 383:269-272. [DOI] [PubMed] [Google Scholar]
- 30a.Kupiec, M. A. S., G. 1985. Arrest of the mitotic cell cycle and of meiosis in Saccharomyces cerevisiae by MMS. Mol. Gen. Genet. 201:558-564. [Google Scholar]
- 31.Le, S., C. Davis, J. B. Konopka, and R. Sternglanz. 1997. Two new S-phase-specific genes from Saccharomyces cerevisiae. Yeast 13:1029-1042. [DOI] [PubMed] [Google Scholar]
- 32.Lee, S. E., F. Paques, J. Sylvan, and J. E. Haber. 1999. Role of yeast SIR genes and mating type in directing DNA double-strand breaks to homologous and non-homologous repair paths. Curr. Biol. 9:767-770. [DOI] [PubMed] [Google Scholar]
- 33.Lewis, L. K., and M. A. Resnick. 2000. Tying up loose ends: nonhomologous end-joining in Saccharomyces cerevisiae. Mutat. Res. 451:71-89. [DOI] [PubMed] [Google Scholar]
- 34.Lundblad, V. 2000. DNA ends: maintenance of chromosome termini versus repair of double-strand breaks. Mutat. Res. 451:227-240. [DOI] [PubMed] [Google Scholar]
- 35.Lusser, A., A. Eberharter, A. Loidl, M. Goralik-Schramel, M. Horngacher, H. Haas, and P. Loidl. 1999. Analysis of the histone acetyltransferase B complex of maize embryos. Nucleic Acids Res. 27:4427-4435. [DOI] [PMC free article] [PubMed] [Google Scholar]
- 36.Ma, X. J., J. Wu, B. A. Altheim, M. C. Schultz, and M. Grunstein. 1998. Deposition-related sites K5/K12 in histone H4 are not required for nucleosome deposition in yeast. Proc. Natl. Acad. Sci. USA 95:6693-6698. [DOI] [PMC free article] [PubMed] [Google Scholar]
- 37.Marmorstein, R., and S. Y. Roth. 2001. Histone acetyltransferases: function, structure, and catalysis. Curr. Opin. Genet. Dev. 11:155-161. [DOI] [PubMed] [Google Scholar]
- 38.Meijer, M., and M. J. Smerdon. 1999. Accessing DNA damage in chromatin: insights from transcription. Bioessays 21:596-603. [DOI] [PubMed] [Google Scholar]
- 39.Mello, J. A., and G. Almouzni. 2001. The ins and outs of nucleosome assembly. Curr. Opin. Genet. Dev. 11:136-141. [DOI] [PubMed] [Google Scholar]
- 40.Melo, J., and D. Toczyski. 2002. A unified view of the DNA-damage checkpoint. Curr. Opin. Cell Biol. 14:237-245. [DOI] [PubMed] [Google Scholar]
- 40a.Milne, G. T., S. Jin, K. B. Shannon, and D. T. Weaver. 1996. Mutations in two Ku homologs define a DNA end-joining repair pathway in Saccharomyces cerevisiae. Mol. Cell. Biol. 16:4189-4198. [DOI] [PMC free article] [PubMed] [Google Scholar]
- 40b.Moore, J. K., and J. E. Haber. 1996. Cell cycle and genetic requirements of two pathways of nonhomologous end-joining repair of double-strand breaks in Saccharomyces cerevisiae Mol. Cell. Biol. 16:2164-2173. [DOI] [PMC free article] [PubMed] [Google Scholar]
- 41.Parthun, M. R., J. Widom, and D. E. Gottschling. 1996. The major cytoplasmic histone acetyltransferase in yeast: links to chromatin replication and histone metabolism. Cell 87:85-94. [DOI] [PubMed] [Google Scholar]
- 42.Paull, T. T., E. P. Rogakou, V. Yamazaki, C. U. Kirchgessner, M. Gellert, and W. M. Bonner. 2000. A critical role for histone H2AX in recruitment of repair factors to nuclear foci after DNA damage. Curr. Biol. 10:886-895. [DOI] [PubMed] [Google Scholar]
- 43.Paulovich, A. G., and L. H. Hartwell. 1995. A checkpoint regulates the rate of progression through S phase in S. cerevisiae in response to DNA damage. Cell 82:841-847. [DOI] [PubMed] [Google Scholar]
- 44.Qian, Y. W., and E. Y. Lee. 1995. Dual retinoblastoma-binding proteins with properties related to a negative regulator of ras in yeast. J. Biol. Chem. 270:25507-25513. [DOI] [PubMed] [Google Scholar]
- 45.Qian, Y. W., Y. C. Wang, R. E. Hollingsworth, Jr., D. Jones, N. Ling, and E. Y. Lee. 1993. A retinoblastoma-binding protein related to a negative regulator of Ras in yeast. Nature 364:648-652. [DOI] [PubMed] [Google Scholar]
- 46.Rogakou, E. P., C. Boon, C. Redon, and W. M. Bonner. 1999. Megabase chromatin domains involved in DNA double-strand breaks in vivo. J. Cell Biol. 146:905-916. [DOI] [PMC free article] [PubMed] [Google Scholar]
- 47.Rogakou, E. P., D. R. Pilch, A. H. Orr, V. S. Ivanova, and W. M. Bonner. 1998. DNA double-stranded breaks induce histone H2AX phosphorylation on serine 139. J. Biol. Chem. 273:5858-5868. [DOI] [PubMed] [Google Scholar]
- 48.Ruiz-Carillo, A., L. J. Wangh, and V. Allfry. 1975. Processing of newly synthesized histone molecules. Science 190:117-128. [DOI] [PubMed] [Google Scholar]
- 48a.Schwartz, J. L. 1989. Monofunctional alkylating agent-induced S-phase-dependent DNA damage. Mutat. Res. 216:111-118. [DOI] [PubMed] [Google Scholar]
- 49.Shen, X., G. Mizuguchi, A. Hamiche, and C. Wu. 2000. A chromatin remodelling complex involved in transcription and DNA processing. Nature 406:541-544. [DOI] [PubMed] [Google Scholar]
- 50.Shibahara, K. I., A. Verrault, and B. Stillman. 2000. The N-terminal domains of histones H3 and H4 are not necessary for chromatin assembly factor-1-mediated nucleosome assembly in vitro. Proc. Natl. Acad. Sci. USA 97:7766-7771. [DOI] [PMC free article] [PubMed] [Google Scholar]
- 51.Shore, D. 2001. Telomeric chromatin: replicating and wrapping up chromosome ends. Curr. Opin. Genet. Dev. 11:189-198. [DOI] [PubMed] [Google Scholar]
- 52.Singer, M. S., A. Kahana, A. J. Wolf, L. L. Meisinger, S. E. Peterson, C. Goggin, M. Mahowald, and D. E. Gottschling. 1998. Identification of high-copy disruptors of telomeric silencing in Saccharomyces cerevisiae. Genetics 150:613-632. [DOI] [PMC free article] [PubMed] [Google Scholar]
- 53.Smith, S., and B. Stillman. 1989. Purification and characterization of CAF-I, a human cell factor required for chromatin assembly during DNA replication in vitro. Cell 58:15-25. [DOI] [PubMed] [Google Scholar]
- 54.Sobel, R. E., R. G. Cook, C. A. Perry, A. T. Annunziato, and C. D. Allis. 1995. Conservation of deposition-related acetylation sites in newly synthesized histones H3 and H4. Proc. Natl. Acad. Sci. USA 92:1237-1241. [DOI] [PMC free article] [PubMed] [Google Scholar]
- 55.Tsukamoto, Y., J. Kato, and H. Ikeda. 1997. Silencing factors participate in DNA repair and recombination in Saccharomyces cerevisiae. Nature 388:900-903. [DOI] [PubMed] [Google Scholar]
- 56.Tyler, J. K., C. R. Adams, S. R. Chen, R. Kobayashi, R. T. Kamakaka, and J. T. Kadonaga. 1999. The RCAF complex mediates chromatin assembly during DNA replication and repair. Nature 402:555-560. [DOI] [PubMed] [Google Scholar]
- 57.Verreault, A. 2000. De novo nucleosome assembly: new pieces in an old puzzle. Genes Dev. 14:1430-1438. [PubMed] [Google Scholar]
- 58.Verreault, A., P. D. Kaufman, R. Kobayashi, and B. Stillman. 1998. Nucleosomal DNA regulates the core-histone-binding subunit of the human Hat1 acetyltransferase. Curr. Biol. 8:96-108. [DOI] [PubMed] [Google Scholar]
- 59.Verreault, A., P. D. Kaufman, R. Kobayashi, and B. Stillman. 1996. Nucleosome assembly by a complex of CAF-1 and acetylated histones H3/H4. Cell 87:95-104. [DOI] [PubMed] [Google Scholar]
- 60.Wan, J. S., R. K. Mann, and M. Grunstein. 1995. Yeast histone H3 and H4 N termini function through different GAL1 regulatory elements to repress and activate transcription. Proc. Natl. Acad. Sci. USA 92:5664-5668. [DOI] [PMC free article] [PubMed] [Google Scholar]
- 60a.Weiffenbach, B., and J. E. Haber. 1981. Homothallic mating type switching generates lethal chromosome breaks in rad52 strains of Saccharomyces cerevisiae. Mol. Cell Biol. 1:522-534. [DOI] [PMC free article] [PubMed] [Google Scholar]
- 61.Weinert, T. A., and L. H. Hartwell. 1988. The RAD9 gene controls the cell cycle response to DNA damage in Saccharomyces cerevisiae. Science 241:317-322. [DOI] [PubMed] [Google Scholar]
- 62.West, S. C. 1997. Processing of recombination intermediates by the RuvABC proteins. Annu. Rev. Genet. 31:213-244. [DOI] [PubMed] [Google Scholar]
- 63.Wilson, J. H., W. Y. Leung, G. Bosco, D. Dieu, and J. E. Haber. 1994. The frequency of gene targeting in yeast depends on the number of target copies. Proc. Natl. Acad. Sci. USA 91:177-181. [DOI] [PMC free article] [PubMed] [Google Scholar]
- 64.Zhang, W., J. R. Bone, D. G. Edmondson, B. M. Turner, and S. Y. Roth. 1998. Essential and redundant functions of histone acetylation revealed by mutation of target lysines and loss of the Gcn5p acetyltransferase. EMBO J. 17:3155-3167. [DOI] [PMC free article] [PubMed] [Google Scholar]